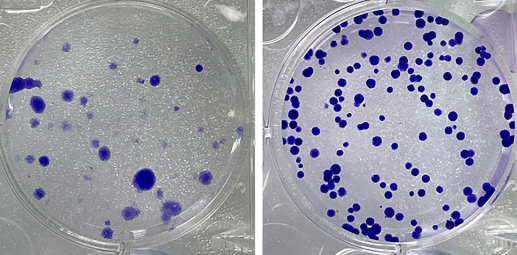
Role and mechanism of KIAA1429 in regulating cellular ferroptosis and radioresistance in colorectal cancer

Role and mechanism of KIAA1429 in regulating cellular ferroptosis and radioresistance in colorectal cancer
DOI:
https://doi.org/10.17305/bb.2024.10313Keywords:
Colorectal cancer, ferroptosis, radioresistance, KIAA1429, lncRNA EBLN3P, miR-153-3p, y-H2AX, m6AAbstract
Colorectal cancer (CRC) is one of the most common non-cutaneous malignancies, causing significant mortality and a substantial burden. This study aims to explore the role of KIAA1429 (also known as vir-like m6A methyltransferase associated [VIRMA]) protein in the radioresistance of CRC. CRC cells and a radioresistant cell line were cultured, and KIAA1429 expression was detected. After the down-regulation of KIAA1429, its effect on the radioresistance and ferroptosis of cancer cells was analyzed. The role of ferroptosis in radioresistance was verified. The binding relationship among long non-coding RNA endogenous Bornavirus-like nucleoprotein 3, pseudogene (lncRNA EBLN3P), microRNA (miR)-153-3p, and KIAA1429 was analyzed. KIAA1429 and lncRNA EBLN3P were highly expressed in CRC, while miR-153-3p was poorly expressed. KIAA1429 and lncRNA EBLN3P were further increased/decreased in the radioresistant cells. KIAA1429 knockdown decreased the survival rate of the radioresistant cell line after X-ray irradiation and increased gamma H2A histone family member X (γ-H2AX), ferroptosis, and oxidative stress. A ferroptosis inhibitor alleviated the inhibitory effect of KIAA1429 knockdown on radioresistance. KIAA1429-mediated m6A modification up-regulated lncRNA EBLN3P, and lncRNA EBLN3P increased KIAA1429 by competitively binding to miR-153-3p. miR-153-3p silencing or lncRNA EBLN3P overexpression attenuated the promotion of ferroptosis and the inhibition of radioresistance induced by KIAA1429 knockdown. Overall, KIAA1429-mediated m6A modification up-regulated lncRNA EBLN3P expression, and lncRNA EBLN3P increased KIAA1429 expression by competitively binding to miR-153-3p, thus reducing ferroptosis and increasing the radioresistance of CRC.
Citations
Downloads
Downloads
Published
Data Availability Statement
The datasets supporting the conclusions of this article are presented in the article. Further inquiries can be directed to the corresponding author.
Issue
Section
Categories
License
Copyright (c) 2024 Hao Chen, Peipei Zhu, Dan Zhu, Juan Jin, Qianni Yang, Xiaodong Han

This work is licensed under a Creative Commons Attribution 4.0 International License.









